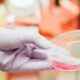

La vaporisation réduit-elle la charge microbienne du cannabis ?

La principale différence entre le cannabis médical et le cannabis récréatif est le besoin d’avoir, dans un usage thérapeutique, une charge microbienne la plus faible possible. Certains patients ont en effet un système immunitaire affaibli et ne peuvent se permettre de consommer un médicament qui pourrait contenir des moisissures ou des microbes nocifs.
La méthode la plus courante est l’administration par vaporisation : des fleurs de cannabis séchées sont chauffées dans un vaporisateur. La vapeur dégagée est ensuite inhalée pour profiter des seuls composés actifs, sans produits délétères liés à une combustion.
L’exposition à des températures élevées, entre 190 et 220°C généralement dans un vaporisateur, est connue pour tuer les micro-organismes, y compris les bactéries et les champignons. Cependant, la mort microbienne dépend de la durée et de la température d’exposition. D’où la nécessité de savoir si un vaporisateur commercial utilisé type Volcano utilisé en milieu clinique diminue de manière significative les charges microbiennes contenu dans du cannabis.
Quel est l’impact de la vaporisation sur la qualité microbiologique du cannabis ?
Pour répondre à cette question, une équipe de chercheurs de la Food and Drug Administration (FDA), l’autorité américaine de régulation de l’alimentaire et du médicament, s’est vu fournir du cannabis par le National Institute on Drug Abuse (NIDA).
Trois types de cannabis ont été utilisés dans l’étude : un placebo sans THC mesurable, du cannabis à faible teneur en THC (1,90 %) et du cannabis à « forte » teneur en THC (6,50 %).
Ils ont ensuite été exposés soit à l’absence de chaleur, soit à un chauffage de 30 ou 70 secondes à 190°C.
Une solution saline tamponnée au phosphate a été ajoutée aux échantillons et ceux-ci ont été agités pour mettre en suspension les micro-organismes. La croissance microbienne après l’absence de chaleur ou la vaporisation a été évaluée en plaçant les échantillons sur des milieux de croissance et en déterminant le nombre total de microbes aérobies et le nombre total de levures et de moisissures.
Les auteurs de l’étude ont finalement conclu que :
- La vaporisation standard de 70 secondes à 190°C n’a pas conduit à une réduction significative de la charge microbienne existante
- Un vaporisateur ne peut être considéré comme efficace pour limiter les risques microbiens associés à la consommation de cannabis par inhalation
- D’autres méthodes de décontamination, telles que l’irradiation gamma, l’irradiation germicide ultraviolette ou la pasteurisation peuvent donc être nécessaires pour limiter la contamination microbienne du Cannabis
-
Businessil y a 3 semaines
Les produits alimentaires CBD vont-ils être interdits le 15 mai ? Le point sur la situation
-
Cannabis en Autricheil y a 4 semaines
Un tribunal autrichien porte un premier coup au projet de monopole du tabac sur les fleurs de chanvre
-
Cannabis en Franceil y a 4 semaines
Portrait : GaléTerpshunter, le breeder discret qui bouscule le CBD français
-
Cannabis en Franceil y a 4 semaines
Snoop Dogg s’invite chez Carrefour : les glaces Dr. Bombay débarquent en France
-
Businessil y a 4 semaines
Allemagne : un magasin de cannabis expérimental bientôt près de Düsseldorf ?
-
Cannabis en Franceil y a 3 semaines
Cannabis médical : 92% des Français pour mais 0 accès
-
Cannabis en Espagneil y a 4 semaines
Spannabis Champions Cup 2026 : les résultats de Bilbao
-
Businessil y a 2 semaines
Bedrocan dévoile Bedromed, une nouvelle gamme de formulations standardisées à base de cannabinoïdes

Vous devez être connectés pour poster un commentaire Connexion